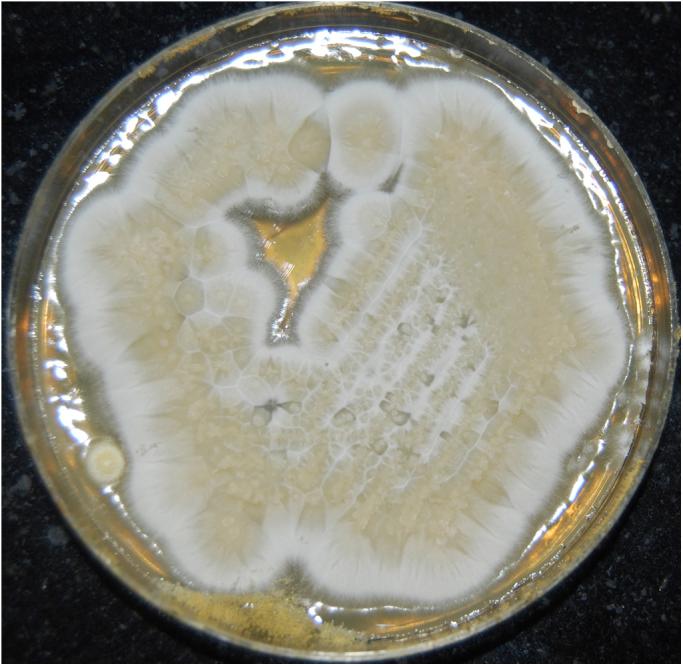

白色丝孢酵母所致肾真菌粪石
Renal fungal bezoar owing to Geotrichum candidum.
作者信息
Yegneswaran Prakash Peralam, Seetaramaiah Venkatesh K, Thomas Joseph, Khanna Vinay, Rao Sugandhi P
机构信息
Department of Microbiology, Medical Mycology Laboratory, Kasturba Medical College-Manipal, Manipal University, Madhav Nagar, Udupi, Manipal, Karnataka 576104, India.
Department of Urology, Kasturba Medical College and Hospital-Manipal, Manipal University, Madhav Nagar, Udupi, Manipal, Karnataka 576104, India.
出版信息
Med Mycol Case Rep. 2012 Aug 29;1(1):63-5. doi: 10.1016/j.mmcr.2012.08.001. eCollection 2012.
Geotrichum candidum is yeast like fungi that cause infections in immunocompromised patients. We report a case of renal fungal ball with Geotrichum candidum in a 27 yr. old women post-partum. This case to our knowledge is the first case of renal fungal bezoar due to Geotrichum candidum reported in India.
白地霉是一种酵母样真菌,可导致免疫功能低下的患者发生感染。我们报告一例产后27岁女性的白地霉肾真菌球病例。据我们所知,该病例是印度报道的首例由白地霉引起的肾真菌粪石病例。